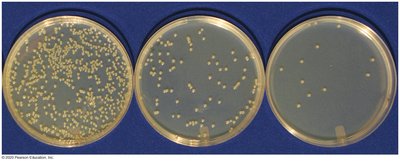
Bacterial colonies on agar plates

Back
BackGenetic Analysis and Mapping in Bacteria and Bacteriophage
Study Guide - Smart Notes

Genetic Analysis and Mapping in Bacteria and Bacteriophage
Introduction
This section explores the mechanisms of genetic recombination and mapping in bacteria and bacteriophages. These processes are fundamental to understanding microbial genetics, gene transfer, and the development of genetic tools used in biotechnology and medicine.
Bacteria Basics
Structure and Growth
Bacteria are prokaryotes with single, circular chromosomes.
They reproduce rapidly by binary fission.
Bacteria can be cultured in liquid media or on agar plates, forming visible colonies from single cells.
Colony counting is used to estimate bacterial concentration via serial dilutions.
Example: Serial dilution plating allows estimation of the number of viable bacteria in a sample by counting colonies and multiplying by the dilution factor.
Prototrophs and Auxotrophs
Prototrophs: Wild-type bacteria that can synthesize all essential organic compounds and grow on minimal media.
Auxotrophs: Mutant bacteria that have lost the ability to synthesize one or more essential compounds and cannot grow on minimal media.
Example: An auxotrophic Escherichia coli strain lacking the ability to synthesize leucine will not grow on minimal media unless leucine is supplied.
Types of Inheritance in Bacteria
Vertical gene transfer: Genetic information is passed from parent to offspring.
Horizontal gene transfer: Genetic information is transferred between unrelated cells, contributing to genetic diversity and antibiotic resistance.
Additional info: Horizontal gene transfer is a major driver of bacterial evolution and speciation.
Genetic Recombination in Bacteria
Overview
Genetic recombination in bacteria leads to new allele combinations and increased genetic diversity. It can result in altered phenotypes and is essential for mapping bacterial chromosomes.
Three main mechanisms: Conjugation, Transformation, and Transduction.
Conjugation
Discovery and Mechanism
Conjugation involves the transfer of genetic material from a donor to a recipient cell via direct contact. This process was discovered by mixing two auxotrophic strains, resulting in prototrophic recombinants.

Key Points:
Physical contact is required for genetic recombination (demonstrated by the Davis U-tube experiment).
Donor cells are F+ (contain the fertility factor), and recipients are F-.
The F factor is a plasmid that enables conjugation.


High Frequency Recombination (Hfr) Strains
Hfr strains are generated when the F factor integrates into the bacterial chromosome, leading to a high rate of recombination. During Hfr x F- mating, chromosomal genes are transferred in a specific order, but the recipient usually remains F-.

Genetic Mapping Using Hfr Bacteria
The interrupted mating technique is used to map bacterial genes. By interrupting conjugation at different times, the order and relative distances of genes can be determined based on the time required for their transfer.



Example: Genes closer to the origin of transfer (O) are transferred first; the time between gene transfers reflects their chromosomal distance.
Transformation
Mechanism and Applications
Transformation is the uptake of free DNA from the environment by a bacterial cell, followed by recombination with the host chromosome. This process can be used for genetic mapping when linked genes are cotransformed.

DNA fragments (10–20 kb) are taken up by competent cells.
Genes close together are more likely to be cotransformed.
Example: Transformation is a key tool in recombinant DNA technology for introducing new genes into bacteria.
Transduction and Bacteriophage
Bacteriophage Structure and Life Cycle
Bacteriophages are viruses that infect bacteria. The T4 phage is a well-studied example with a complex structure and a lytic life cycle.


Lytic cycle: Phage replicates and lyses the host cell.
Lysogenic cycle: Phage DNA integrates into the host genome and replicates with it until induced to enter the lytic cycle.
Transduction
Transduction is the transfer of bacterial genes by bacteriophages. The Lederberg-Zinder experiment demonstrated that recombination could occur without cell contact, implicating a "filterable agent" (phage).

Genes close together are more likely to be cotransduced.

Example: Transduction is used to map bacterial genes based on the frequency of cotransduction.
Summary Table: Mechanisms of Genetic Exchange in Bacteria
Mechanism | Key Features | Mapping Utility |
|---|---|---|
Conjugation | Direct cell-to-cell contact; F factor; Hfr strains | Order and timing of gene transfer |
Transformation | Uptake of free DNA; recombination with host chromosome | Cotransformation frequency |
Transduction | Phage-mediated gene transfer | Cotransduction frequency |
